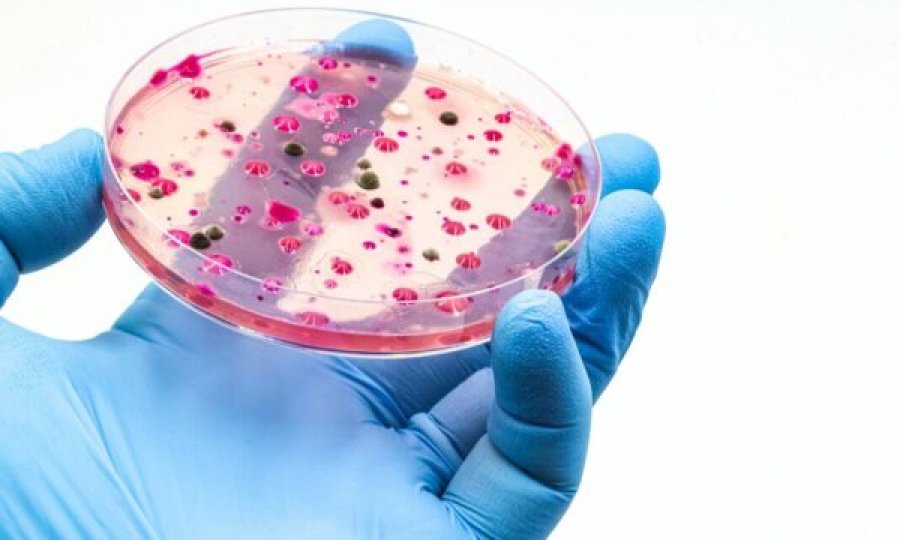
Kërpudha vdekjeprurëse po përhapet globalisht dhe po bëhet më infektuese

Lexoni edhe:
Agnesa Vuthaj ka njoftuar se është shtatzënë
Shkencëtarët kanë lëshuar një paralajmërim serioz pas publikimit të një studimi të ri që tregon se një kërpudhë e rrezikshme, rezistente ndaj barnave, po përhapet me shpejtësi në mbarë botën dhe po zhvillon tipare që e bëjnë gjithnjë e më të vështirë trajtimin e saj.
Bëhet fjalë për Candida auris, një maja invazive që prek kryesisht personat me sistem imunitar të dobësuar. Kjo kërpudhë tashmë është identifikuar në më shumë se 60 shtete, përfshirë edhe Mbretërinë e Bashkuar.
Agnesa Vuthaj ka njoftuar se është shtatzënë
Lexoni edhe:
Infeksionet fungale në përgjithësi prekin rreth 6.5 milionë njerëz çdo vit dhe lidhen me shkallë vdekshmërie mbi 50%, edhe kur trajtimi antifungal është i disponueshëm. Studiuesit theksojnë se C. auris është veçanërisht shqetësuese sepse përhapet lehtë në ambientet spitalore, është shpesh rezistente ndaj disa llojeve të ilaçeve antifungale dhe po bëhet gjithnjë e më virulente.
Një rishikim shkencor i botuar në revistën Nature Microbiology vuri në dukje disa karakteristika që i mundësojnë kësaj kërpudhe të përhapet me efikasitet. Ndër to është aftësia për të ndryshuar formë – nga strukturë e ngjashme me majanë në forma të tjera që ndihmojnë pushtimin e indeve dhe rritjen e rezistencës ndaj barnave. Proteina të specializuara i lejojnë gjithashtu të ngjitet fort në lëkurë.
Sipas studiuesve:
“Kolonizimi i lëkurës nga C. auris përbën një shqetësim serioz mjekësor, sepse pacientët e kolonizuar mund të lehtësojnë transmetimin e kërpudhës brenda dhe ndërmjet spitaleve tek pacientë të tjerë.”
Kërpudha mund të mbijetojë për periudha të gjata në sipërfaqe dhe në pajisje mjekësore, ndaj shpërthimet lidhen shpesh me përdorimin e kateterëve, tubave ushqyes dhe ventilatorëve. Ajo bartet në lëkurë dhe në lëngjet trupore dhe mund të shkaktojë infeksione serioze në gjak, plagë dhe veshë. Në disa raste, individët mund ta mbajnë kërpudhën pa shfaqur simptoma.
Studimi thekson gjithashtu se diagnostikimi i C. auris shpesh pengohet nga keqidentifikimi laboratorik, gjë që çon në vonesa në nisjen e trajtimit të duhur. Studiuesit nënvizojnë nevojën urgjente për zhvillimin e barnave të reja antifungale me spektër të gjerë, përmirësimin e testeve diagnostikuese dhe zhvillimin e qasjeve mbështetëse imunologjike dhe vaksinave për pacientët me rrezik të lartë.
Simptomat shpesh ngatërrohen me ato të infeksioneve bakteriale, si temperatura e lartë dhe të dridhurat, por ato ndryshojnë në varësi të zonës së trupit të prekur. Jashtë Mbretërisë së Bashkuar, infeksionet invazive të rënda lidhen me vdekshmëri të lartë, sipas paralajmërimit të Agjencisë së Sigurisë Shëndetësore të Mbretërisë së Bashkuar (UKHSA).
Në Angli, rastet e konfirmuara mbeten relativisht të pakta, por janë në rritje. Të dhënat e UKHSA tregojnë se 637 raste u raportuan mes janarit 2013 dhe dhjetorit 2024. Vetëm 26 raste u regjistruan në vitin 2021, 38 në 2022, 93 në 2023, ndërsa numri u rrit ndjeshëm në 178 raste në vitin 2024.
Dr. Rohini Manuel, mikrobiologe konsulente pranë UKHSA, deklaroi më herët këtë vit:
“Shkalla e rasteve të C. auris në spitalet e Anglisë është ende shumë e ulët, por është rritur vitet e fundit. Të dhënat përfshijnë si infeksionet, ashtu edhe kolonizimet, që do të thotë se kërpudha është e pranishme në lëkurë, por nuk shkakton domosdoshmërisht sëmundje.”
Ajo shtoi se UKHSA po punon ngushtë me Shërbimin Kombëtar të Shëndetësisë (NHS) për të hetuar arsyet e rritjes, të cilat mund të lidhen me përhapjen globale të kërpudhës. Shpërthimet spitalore në vend mbeten të rralla, por disa institucione po mbështeten në menaxhimin e rasteve të kolonizimit, në forcimin e masave të parandalimit të infeksioneve dhe në ruajtjen e sigurisë së pacientëve.
(Kosova Sot Online)
